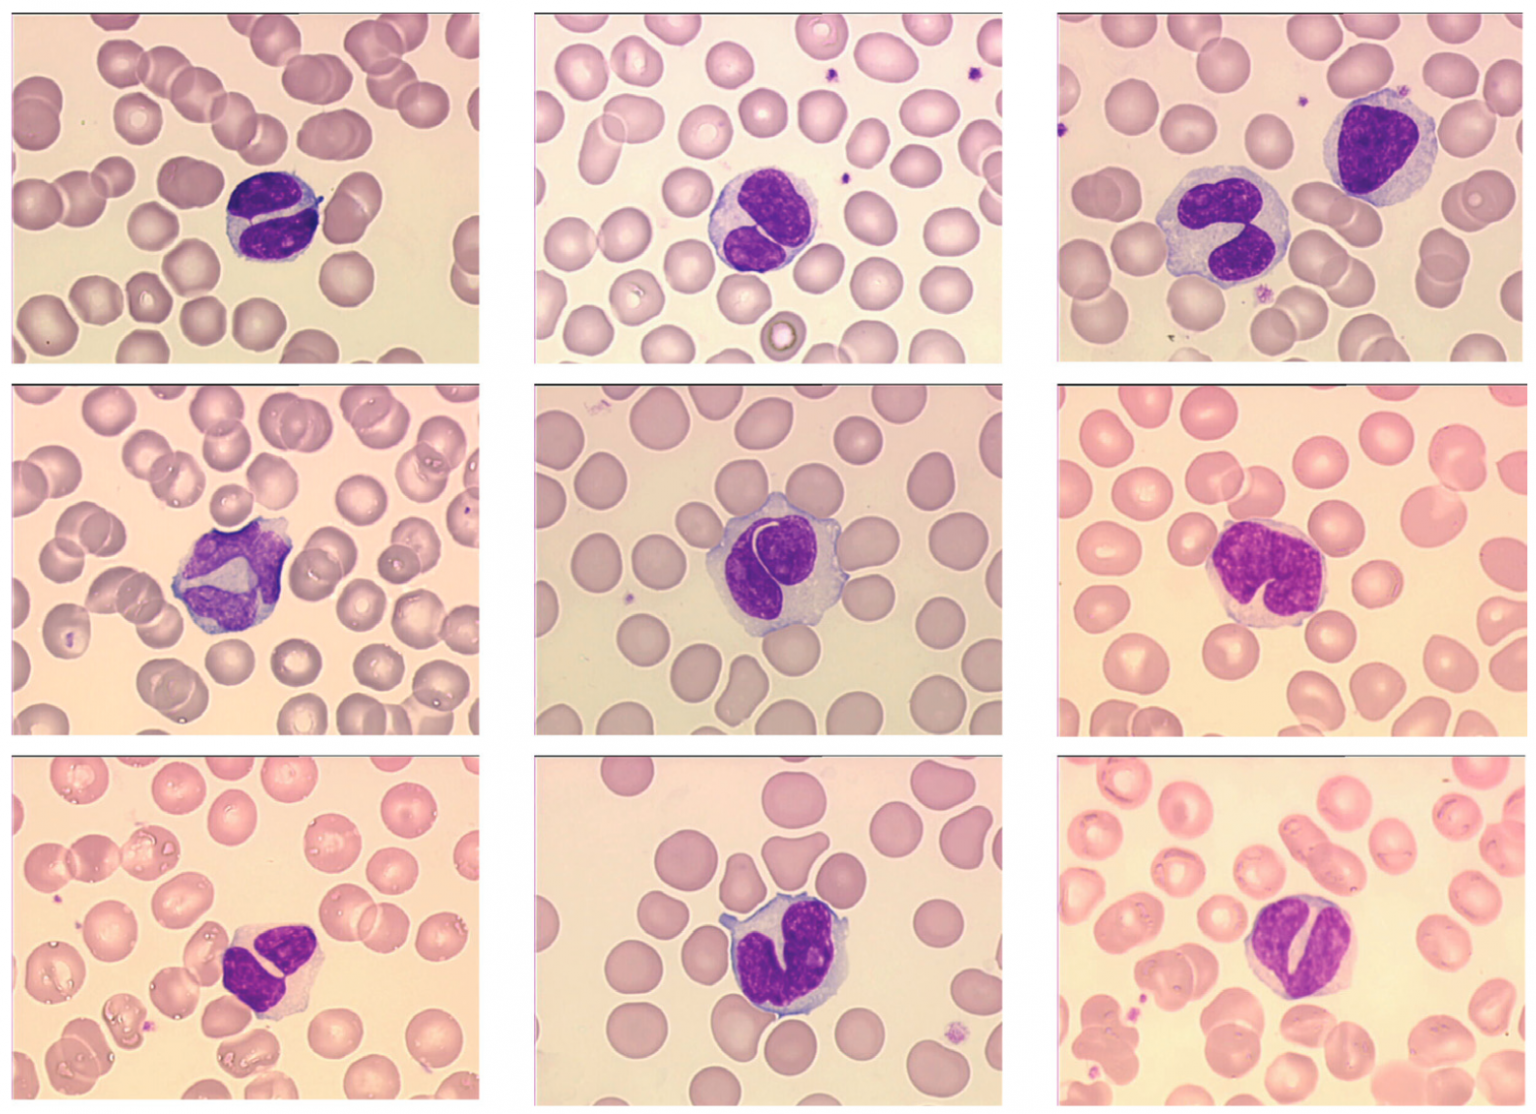

Reactive Lymphocytes / Benign Disorders LearnHaem Haematology Made - Reactive lymphocytes seen on a blood film indicates that the most likely cause is infection, typically viral. Rare reactive lymphocytes are visible in blood smears from healthy animals, whereas a few to several reactive lymphocytes may occur in blood smears from sick or recently vaccinated. Atypical lymphocytes, also known as reactive lymphocytes, are enlarged white blood cells that can be. You should also read this: How Long Are Binax Covid Tests Good For

Blood film showing reactive lymphocytosis Blood film showing a reactive - Evaluation of a peripheral blood smear is recommended to evaluate the morphology of the lymphocytes. Delivery to 80+ countriesview servicesorder 24 hrs a dayexplore resources Typically they can be more than 30 µm in diameter with varying size and shape. For reactive lymphocytosis, there is a wide range of lymphocyte morphologies within a given blood smear. In immunology, reactive lymphocytes,. You should also read this: Pharmacologic Nuclear Stress Test

Reactive Lymphocytes in Peripheral Blood, Infectious Monon… Flickr - In immunology, reactive lymphocytes, variant lymphocytes, atypical lymphocytes, downey cells or türk cells are cytotoxic (cd8 ) lymphocytes that become large as a result of antigen stimulation. Large reactive (atypical) lymphocytes that represent activated t cells. Typically, they can be more than 30 μm in diameter with varying size and shape. Both reactive and malignant lymphocytosis can present with a. You should also read this: Free Well Water Testing Maine

Representative images of typical reactive lymphocytes in the peripheral - Inflammation is integral to the onset and. They check the number of lymphocytes in your blood. Reactive lymphocytes are seen in peripheral blood as a response to antigenic stimulation. Reactive lymphocytes in an older dog with atrial hemangiosarcoma. Large reactive (atypical) lymphocytes that represent activated t cells. You should also read this: Naturalization Test Answers And Questions

Reactive lymphocytes eClinpath - In immunology, reactive lymphocytes, variant lymphocytes, atypical lymphocytes, downey cells or türk cells are cytotoxic (cd8 ) lymphocytes that become large as a result of antigen stimulation. Atypical lymphocytes, also known as reactive lymphocytes, are enlarged white blood cells that can be a sign of an immune response to an infection or other illness. Typically, they can be more than. You should also read this: Do They Test For Hpv In Pregnancy
Reactive lymphocyte - Atypical lymphocytes, also known as reactive lymphocytes, are enlarged white blood cells that can be a sign of an immune response to an infection or other illness. Circulating reactive lymphocytes supports a diagnosis of antigenic stimulation. The cytoplasm shows characteristic basophilic skirting in areas where there is contact with red blood cells. They check the number of lymphocytes in your. You should also read this: Dld.utah.gov Skills Test

Classifying Microscopic Images of Reactive Lymphocytosis Using TwoStep - Thus, they are more frequently. Atypical lymphocytes, also known as reactive lymphocytes, are enlarged white blood cells that can be a sign of an immune response to an infection or other illness. Reactive lymphocytes are lymphocytes that become large as a result of antigen stimulation. In immunology, reactive lymphocytes, variant lymphocytes, atypical lymphocytes, downey cells or türk cells are cytotoxic. You should also read this: Jnw Test Strips

Lymphocytes Blood Film MedSchool - Reactive lymphocytes seen on a blood film indicates that the most likely cause is infection, typically viral. Reactive lymphocytes are seen in peripheral blood as a response to antigenic stimulation. In immunology, reactive lymphocytes, variant lymphocytes, atypical lymphocytes, downey cells or türk cells are cytotoxic (cd8 ) lymphocytes that become large as a result of antigen stimulation. Additionally, a peripheral. You should also read this: Drug Test Thc Calculator
Reactive Lymphocytes / Benign Disorders LearnHaem Haematology Made - Atypical lymphocytes, also known as reactive lymphocytes, are enlarged white blood cells that can be a sign of an immune response to an infection or other illness. Evaluation of a peripheral blood smear is recommended to evaluate the morphology of the lymphocytes. “that’s the major feature you’re looking for,” he said, noting in fig. Additionally, a peripheral blood smear is. You should also read this: Does Costco Sell Covid Test Kits

Reactive Lymphocytes / Benign Disorders LearnHaem Haematology Made - They check the number of lymphocytes in your blood. Delivery to 80+ countriesview servicesorder 24 hrs a dayexplore resources Circulating reactive lymphocytes supports a diagnosis of antigenic stimulation. Inflammation is integral to the onset and. Increased numbers of large granular lymphocytes (reactive lymphocytes with scattered azurophilic granules) are commonly seen with viral infections, malignancy, after. You should also read this: Tb Test Without Insurance